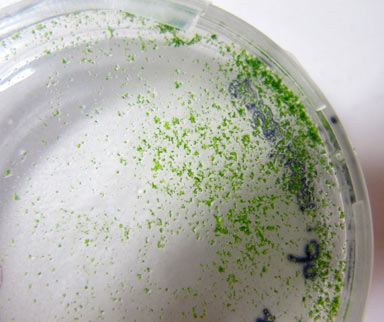
APII jpeg image of Sphagnum cristatum  © contact APII

enlarge image ©
©
Sphagnum cristatum
Young sporelings of Sphagnum growing on Phytogel.
Photographer: Cargill, D.C.
Copyright holder: Other, see our image use page for details
Date Taken: 09 August 2013
Taken at: Chris Cargill's Office, Botany Building, ANBG
Image Source: Australian Plant Image Index (APII) - Photo No.: dig.23596
©
©

